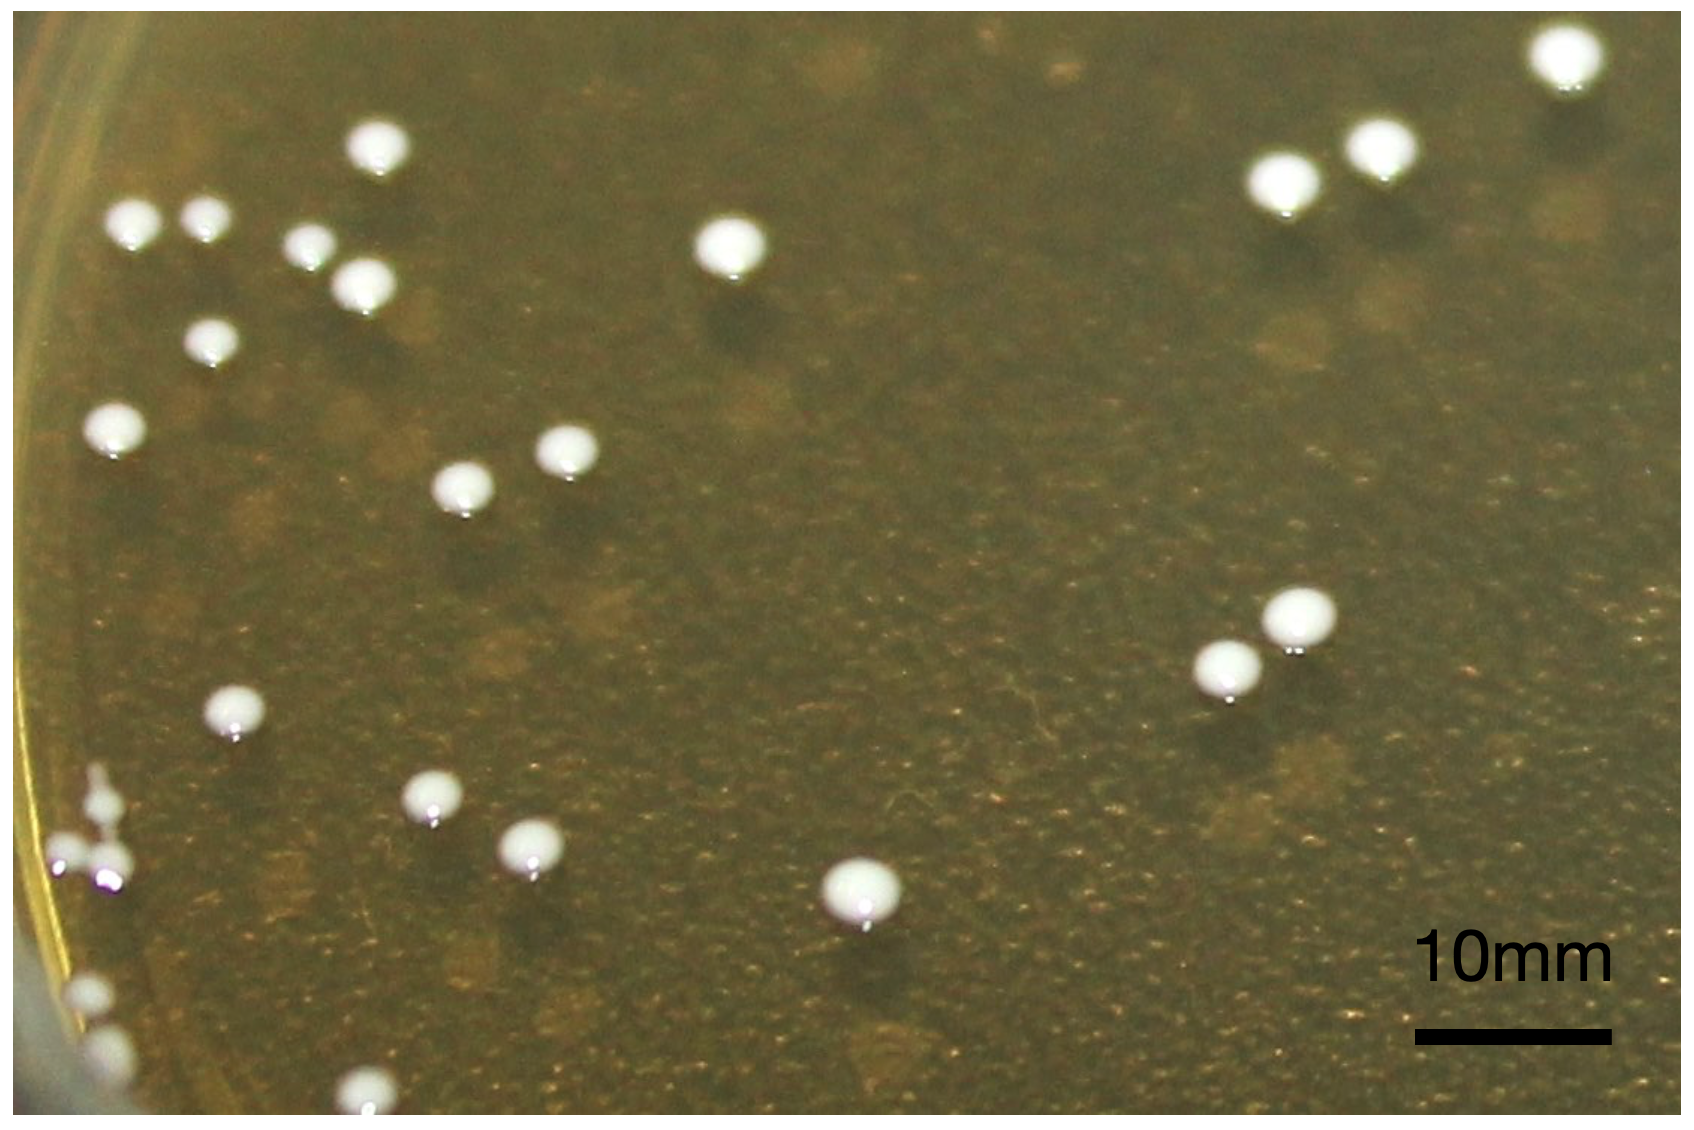
PSL%202019%20Special%20Issue%2008 Macalinao%20et%20al

Philipp. Sci. Lett. 2020 13 (Supplement) 014-023
available online: July 29, 2020
*Corresponding author
Email Address: nicdao.michaelangelo@gmail.com
Date received: January 15, 2020
Date revised: March 26, 2020
Date accepted: March 28, 2020
The ciprofloxacin resistance of Lactobacillus species isolated from probiotic food products in the Philippines is due to mutations in gyrB and parC genes
The consumption of probiotic products in the Philippines is prevalent, with more than 2.7 million bottles of a single product consumed per day. Probiotics are microorganisms that are administered for their beneficial activity on animal and human health. On one hand, there are some concerns on probiotics as potential conduits of lateral antibiotic resistance gene transfer to gut pathogens. On the other hand, probiotics are also being tapped as potential cell-based therapeutics against pathogens to augment the antimicrobial activity of antibiotics. Therefore, it is of interest to the general public for widely consumed probiotics to be assessed for their susceptibility to antibiotics that are medically important in the country. In this study, the antibiotic susceptibilities of probiotic bacteria that were isolated from commercial food products in the Philippines were assessed. Three Lactobacillus species — L. paracasei, L. casei, and L. delbrueckii subsp. bulgaricus, were isolated from probiotic food products. A modified agar well diffusion method and a minimum inhibitory concentration (MIC) microdilution assay were utilized to test these isolates. Our results demonstrated that the isolated species of Lactobacillus bacteria are more susceptible to amoxicillin and doxycycline than the reference bacteria, Escherichia coli (ATCC 25922). These findings suggest that they likely do not harbor transferrable resistance genes to these antibiotics. However, we also found that the isolates are recalcitrant to ciprofloxacin, which is likely due to mutations in their gyrB and parC. These are chromosomal genes that encode for the target enzyme of ciprofloxacin. Therefore, with their ciprofloxacin resistance genes being chromosomal in nature, the odds of lateral transfer of ciprofloxacin resistance genes to gut pathogens is less compared to plasmid-encoded resistance genes. We believe that routine antibiotic resistance profiling should be conducted on probiotic microorganisms that are widely consumed as food products or feed supplement in agricultural industries. This will provide valuable information to reduce risks and maximize the benefits of probiotics.
© 2026 SciEnggJ
Philippine-American Academy of Science and Engineering